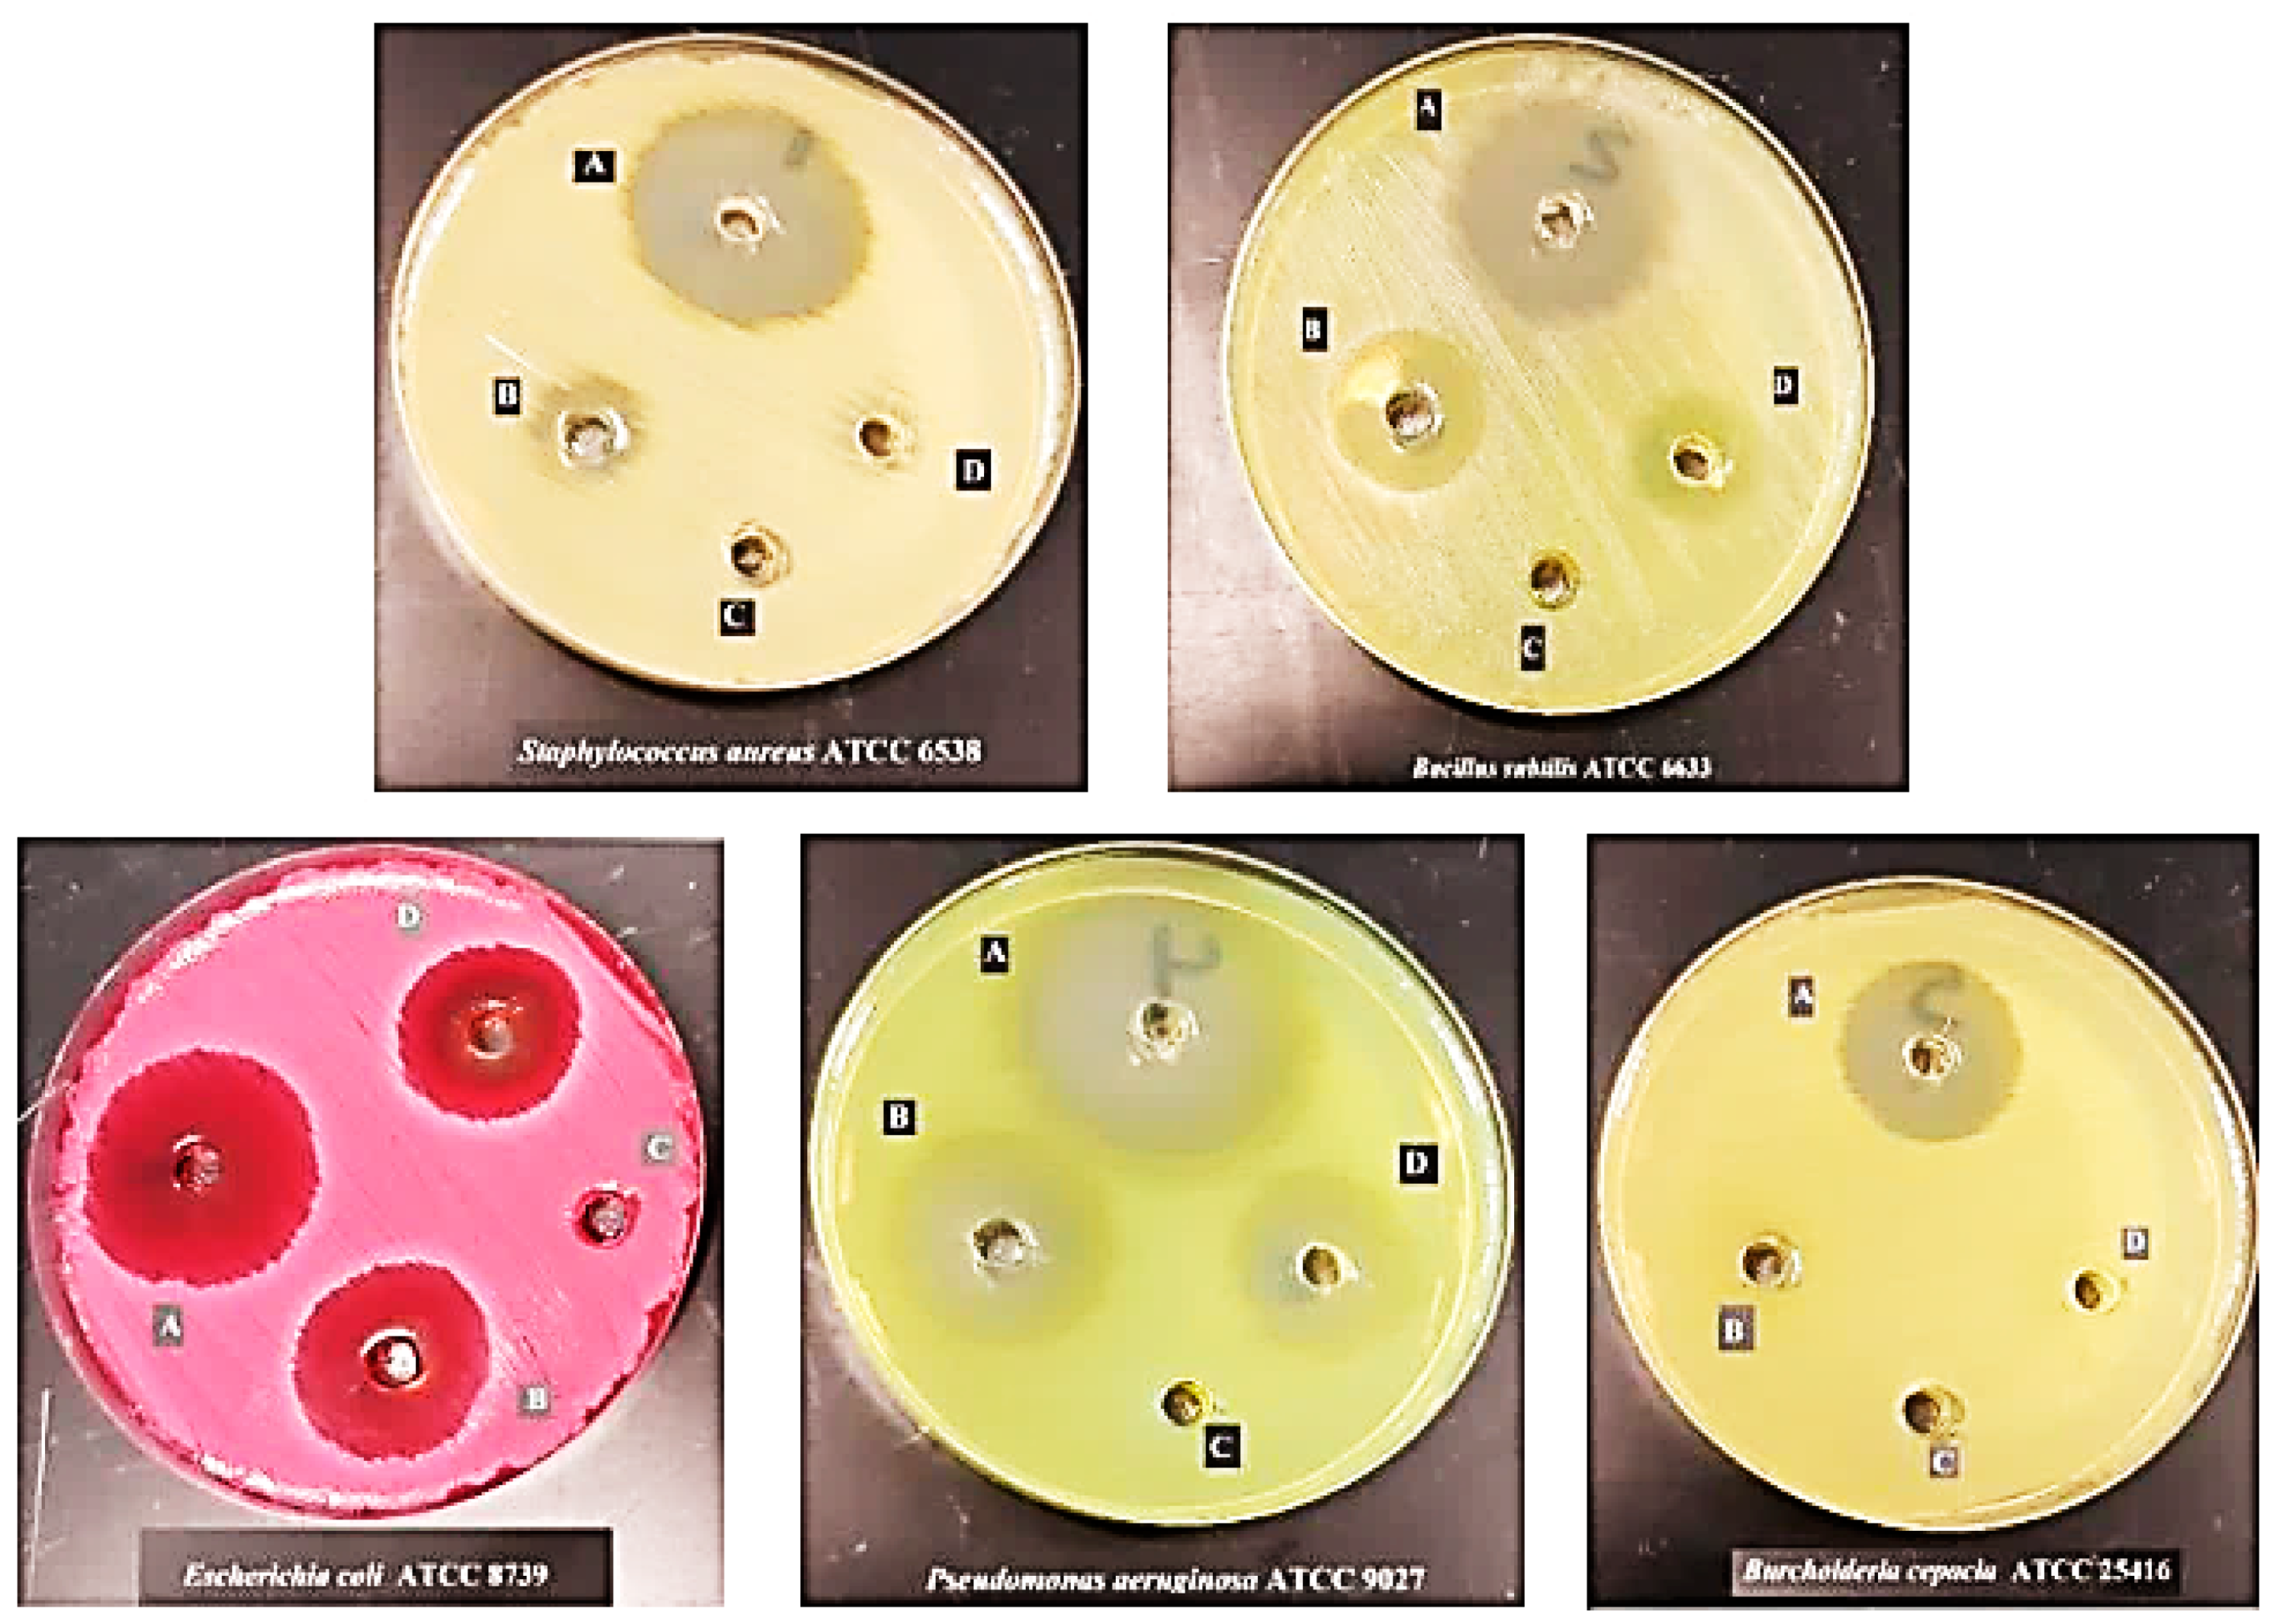
Ijms 24 14818 g007

Synthesis, Physicochemical Characterization using a Facile Validated HPLC Quantitation Analysis Method of 4-Chloro-phenylcarbamoyl-methyl Ciprofloxacin and Its Biological Investigations
Abstract
:1. Introduction
2. Results and Discussion
2.1. FTIR Analysis
2.2. UV-Vis Spectroscopy Identification
2.3. TEM and SEM Analysis
2.4. 1H NMR and 13C NMR for Cpx-Drv “1-Cyclopropyl-6-fluoro-4-oxo-7-(4-(2-oxo-2-(4-chlorophenyl)amino)ethyl) piperazin-1-yl)-1,4-dihydroquinoline-3carboxylic Acid”
2.5. Water Content Determination
2.6. HPLC Quantitative, Qualitative Analysis, and Method Validation Check
2.7. Antimicrobial Activity
2.8. DNA Gyrase and Topoisomerase IV Inhibition Assays
2.9. Docking Studies
2.10. Anticancer Activity
3. Materials and Methods
3.1. Materials
3.2. Synthesis of the Target Compound Cpx-Drv
3.3. Characterizations
3.4. HPLC Quantitative, Qualitative Analysis and Method Validation Check
3.4.1. Chromatographic System Configuration
3.4.2. System Suitability Check
3.4.3. Linearity and Range
3.4.4. LOD and LOQ
3.4.5. Accuracy and Recovery
3.4.6. Precision (Repeatability and Intermediate Precision)
3.4.7. Specificity and Selectivity
3.5. Antimicrobial Activity
3.5.1. Agar Well Diffusion Method
3.5.2. Antimicrobial Activity Bioassay
3.6. Topoisomerase II Inhibition Assays
3.6.1. S. aureus Gyrase Supercoiling Assay
3.6.2. S. aureus Topoisomerase IV Decatenation Assay
3.7. Docking Studies
3.8. Anticancer Activity
4. Conclusions
Author Contributions
Funding
Institutional Review Board Statement
Informed Consent Statement
Data Availability Statement
Acknowledgments
Conflicts of Interest
References
- Al-Hakkani, M.F.; Gouda, G.A.; Hassan, S.H.A.; Saddik, M.S.; El-Mokhtar, M.A.; Ibrahim, M.A.; Mohamed, M.M.A.; Nagiub, A.M. Cefotaxime removal enhancement via bio- nanophotocatalyst α-Fe2O3 using photocatalytic degradation technique and its echo-biomedical applications. Sci. Rep. 2022, 12, 11881. [Google Scholar] [CrossRef] [PubMed]
- Hunge, Y.M.; Yadav, A.A.; Kang, S.-W.; Jun Lim, S.; Kim, H. Visible light activated MoS2/ZnO composites for photocatalytic degradation of ciprofloxacin antibiotic and hydrogen production. J. Photochem. Photobiol. A 2023, 434, 114250. [Google Scholar] [CrossRef]
- Al-Hakkani, M.F.; Gouda, G.A.; Hassan, S.H.A.; Mohamed, M.M.A.; Nagiub, A.M. Environmentally azithromycin pharmaceutical wastewater management and synergetic biocompatible approaches of loaded azithromycin@hematite nanoparticles. Sci. Rep. 2022, 12, 10970. [Google Scholar] [CrossRef] [PubMed]
- Ali, S.; Perveen, S.; Shah, M.R.; Zareef, M.; Arslan, M.; Basheer, S.; Ullah, S.; Ali, M. Bactericidal potentials of silver and gold nanoparticles stabilized with cefixime: A strategy against antibiotic-resistant bacteria. J. Nanopart. Res. 2020, 22, 201. [Google Scholar] [CrossRef]
- Khan, K.M.; Siddiqui, R.; Ambreen, N.; Sultana, N.; Tauseef, S.; Ahmad, A.; Perveen, S. Synthesis, antibacterial, and antifungal evaluation of norfloxacin derivatives. J. Pharm. Res. 2012, 5, 666–671. [Google Scholar]
- Dey, R.; Bishayi, B. Dexamethasone along with ciprofloxacin modulates S. aureus induced microglial inflammation via glucocorticoid (GC)-GC receptor-mediated pathway. Microb. Pathog. 2020, 145, 104227. [Google Scholar] [CrossRef]
- Pudlo, M.; Luzet, V.; Ismaïli, L.; Tomassoli, I.; Iutzeler, A.; Refouvelet, B. Quinolone–benzylpiperidine derivatives as novel acetylcholinesterase inhibitor and antioxidant hybrids for Alzheimer Disease. Bioorg. Med. Chem. 2014, 22, 2496–2507. [Google Scholar] [CrossRef]
- Dalhoff, A. Antiviral, antifungal, and antiparasitic activities of fluoroquinolones optimized for treatment of bacterial infections: A puzzling paradox or a logical consequence of their mode of action? Eur. J. Clin. Microbiol. Infect. Dis. 2015, 34, 661–668. [Google Scholar] [CrossRef]
- Li, J.; Li, S.; Bai, C.; Liu, H.; Gramatica, P. Structural requirements of 3-carboxyl-4 (1H)-quinolones as potential antimalarials from 2D and 3D QSAR analysis. J. Mol. Graph. Model. 2013, 44, 266–277. [Google Scholar] [CrossRef] [PubMed]
- Mohammed, H.H.; Abbas, S.H.; Hayallah, A.M.; Abuo-Rahma, G.E.-D.A.; Mostafa, Y.A. Novel urea linked ciprofloxacin-chalcone hybrids having antiproliferative topoisomerases I/II inhibitory activities and caspases-mediated apoptosis. Bioorg. Chem. 2021, 106, 104422. [Google Scholar] [CrossRef]
- Shabani, F.; Saghatforoush, L.A.; Ghammamy, S. Synthesis, characterization and anti-tumour activity of Iron (III) Schiff base complexes with unsymmetric tetradentate ligands. Bull. Chem. Soc. Ethiop. 2010, 24, 193–199. [Google Scholar] [CrossRef]
- Nunes, B.; Leal, C.; Rodrigues, S.; Antunes, S.C. Assessment of ecotoxicological effects of ciprofloxacin in Daphnia magna: Life-history traits, biochemical and genotoxic effects. Water Sci. Technol. 2018, 2017, 835–844. [Google Scholar] [CrossRef] [PubMed]
- Cacicedo, M.L.; Pacheco, G.; Islan, G.A.; Alvarez, V.A.; Barud, H.S.; Castro, G.R. Chitosan-bacterial cellulose patch of ciprofloxacin for wound dressing: Preparation and characterization studies. Int. J. Biol. Macromol. 2020, 147, 1136–1145. [Google Scholar] [CrossRef] [PubMed]
- Moharram, A.; Ismail, M.; Shoreit, A.; Hassan, M. Biodiversity of microbiota in cephalosporin-manufacturing environments at T3A factory, Assiut, Egypt. J. Basic Appl. Mycol. 2014, 5, 1–13. [Google Scholar]
- Hassan, M.; Ismail, M.; Moharram, A.; Shoreit, A. Synergistic Effect of Biogenic Silver-nanoparticles with β lactam Cefotaxime against Resistant Staphylococcus arlettae AUMC b-163 Isolated from T3A Pharmaceutical Cleanroom, Assiut, Egypt. Am. J. Microbiol. Res. 2016, 4, 132–137. [Google Scholar]
- Seeman, P. The Membrane Actions of Anesthetics and Tranquilizers. Pharmacol. Rev. 1972, 24, 583–655. [Google Scholar]
- Cho, K.-H.; Park, J.-E.; Osaka, T.; Park, S.-G. The study of antimicrobial activity and preservative effects of nanosilver ingredient. Electrochim. Acta 2005, 51, 956–960. [Google Scholar] [CrossRef]
- Azhdarzadeh, M.; Lotfipour, F.; Zakeri-Milani, P.; Mohammadi, G.; Valizadeh, H. Anti-bacterial performance of azithromycin nanoparticles as colloidal drug delivery system against different gram-negative and gram-positive bacteria. Adv. Pharm. Bull. 2012, 2, 17. [Google Scholar]
- Rong, X.; Qiu, F.; Jiang, Z.; Rong, J.; Pan, J.; Zhang, T.; Yang, D. Preparation of ternary combined ZnO-Ag2O/porous g-C3N4 composite photocatalyst and enhanced visible-light photocatalytic activity for degradation of ciprofloxacin. Chem. Eng. Res. Des. 2016, 111, 253–261. [Google Scholar] [CrossRef]
- Mocanu, A.-G.; Belu, I.; Croitoru, O.; Ciocîlteu, M.V.; Manda, C.; Neamtu, J. Formulation and characterization of ciprofloxacin loaded PLGA microspheres for applications in orthopedic infections. Curr. Health Sci. J. 2017, 43, 306. [Google Scholar]
- Mohammed, H.H.; Abd El-Hafeez, A.A.; Abbas, S.H.; Abdelhafez, E.-S.M.; Abuo-Rahma, G.E.-D.A. New antiproliferative 7-(4-(N-substituted carbamoylmethyl) piperazin-1-yl) derivatives of ciprofloxacin induce cell cycle arrest at G2/M phase. Bioorg. Med. Chem. 2016, 24, 4636–4646. [Google Scholar] [CrossRef] [PubMed]
- Moosa, M.H.; Abu-Okail, M.; Abu-Oqail, A.; Al-Shelkamy, S.A.; Shewakh, W.M.; Ghafaar, M.A. Structural and Tribological Characterization of Carbon and Glass Fabrics Reinforced Epoxy for Bushing Applications Safety. Polymers 2023, 15, 2064. [Google Scholar] [CrossRef] [PubMed]
- Al-Hakkani, M.F.; Ahmed, N.; Hassan, M.H.A. Rapidly, sensitive quantitative assessment of thiopental via forced stability indicating validated RP-HPLC method and its in-use stability activities. Sci. Rep. 2023, 13, 10294. [Google Scholar] [CrossRef]
- Al-Hakkani, M.F.; Ahmed, N.; Abbas, A.A.; Hassan, M.H.A. Cefoperazone rapidly and sensitive quantitative assessment via a validated RP-HPLC method for different dosage forms, in-use stability, and antimicrobial activities. BMC Chem. 2023, 17, 72. [Google Scholar] [CrossRef] [PubMed]
- Al-Hakkani, M.F. A new validated facile HPLC analysis method to determine methylprednisolone including its derivatives and practical application. Sci. Rep. 2023, 13, 11548. [Google Scholar] [CrossRef]
- ICH Steering Committee. ICH Q2B Validation of Analytical Procedures: Methodology; European Agency for the Evaluation of Medicinal Products: London, UK, 1996; Volume 281, p. 95. [Google Scholar]
- Tripartite, G.I.H. Validation of analytical procedures: Text and methodology. Q2 (R1) 2005, 1, 11–12. [Google Scholar]
- AHMA, G.E.D.A.; Abbas, S.; Shoman, M.; SAMIR, I.; EL-BAKY, R.A. New $ N $-4 piperazinyl derivatives of norfloxacin: Design, synthesis, and correlation of calculated physicochemical parameters with antibacterial activity. Turk. J. Chem. 2018, 42, 1072–1085. [Google Scholar]
- Vazquez, J.; Merino, S.; Doměnech, Ò.; Berlanga, M.; Vinas, M.; Montero, M. Hernandez-Borrell: Determination of the partition coefficients of a homologous series of ciprofloxacin: Influence of the N-4 piperazinyl alkylation on the antimicrobial activity. Int. J. Pharm. 2001, 220, 53–62. [Google Scholar] [CrossRef]
- Bhaskaran, N.A.; Kumar, L.; Reddy, M.S.; Pai, G.K. An analytical “quality by design” approach in RP-HPLC method development and validation for reliable and rapid estimation of irinotecan in an injectable formulation. Acta Pharm. 2021, 71, 57–79. [Google Scholar] [CrossRef]
- Shabir, G.A. Step-by-step analytical methods validation and protocol in the quality system compliance industry. J. Val. Technol. 2005, 10, 314–325. [Google Scholar]
- Devaraj, S.; Sivaperuman, A.; Nagarajan, N.C. RP-UPLC Method Development and Validation for Simultaneous Estimation of Mometasone Furoate and Miconazole Nitrate in Semisolid Dosage Form. Acta Pharm. Sci. 2020, 58, 335. [Google Scholar] [CrossRef]
- Alangari, A.; Alqahtani, M.S.; Mateen, A.; Kalam, M.A.; Alshememry, A.; Ali, R.; Kazi, M.; AlGhamdi, K.M.; Syed, R. Iron Oxide Nanoparticles: Preparation, Characterization, and Assessment of Antimicrobial and Anticancer Activity. Adsorpt. Sci. Technol. 2022, 2022, 1562051. [Google Scholar] [CrossRef]
- Arsalani, N.; Mashkouri, S.; Hosseini, M.G.; Ramazani, A.; Mostafavi, H. Green synthesis of water-soluble graphene nanosheets under solvent-free condition and in-situ anchored with MnO2 as supercapacitor. J. Mater. Sci. Mater. Electron. 2018, 29, 6692–6701. [Google Scholar] [CrossRef]
- Ocsoy, I.; Temiz, M.; Celik, C.; Altinsoy, B.; Yilmaz, V.; Duman, F. A green approach for formation of silver nanoparticles on magnetic graphene oxide and highly effective antimicrobial activity and reusability. J. Mol. Liq. 2017, 227, 147–152. [Google Scholar] [CrossRef]
- Mukherjee, D.; Ghosh, S.; Majumdar, S.; Annapurna, K. Green synthesis of α-Fe2O3 nanoparticles for arsenic(V) remediation with a novel aspect for sludge management. J. Env. Chem. Eng. 2016, 4, 639–650. [Google Scholar] [CrossRef]
- Amer, M.W.; Awwad, A.M. Green synthesis of copper nanoparticles by Citrus limon fruits extract, characterization and antibacterial activity. Chem. Int. 2021, 7, 1–8. [Google Scholar]
- Madubuonu, N.; Aisida, S.O.; Ali, A.; Ahmad, I.; Zhao, T.-K.; Botha, S.; Maaza, M.; Ezema, F.I. Biosynthesis of iron oxide nanoparticles via a composite of Psidium guavaja-Moringa oleifera and their antibacterial and photocatalytic study. J. Photochem. Photobiol. B 2019, 199, 111601. [Google Scholar] [CrossRef]
- Rodriguez-Mozaz, S.; Chamorro, S.; Marti, E.; Huerta, B.; Gros, M.; Sànchez-Melsió, A.; Borrego, C.M.; Barceló, D.; Balcázar, J.L. Occurrence of antibiotics and antibiotic resistance genes in hospital and urban wastewaters and their impact on the receiving river. Water Res. 2015, 69, 234–242. [Google Scholar] [CrossRef]
- Ziko, L.; Saqr, A.-H.A.; Ouf, A.; Gimpel, M.; Aziz, R.K.; Neubauer, P.; Siam, R. Antibacterial and anticancer activities of orphan biosynthetic gene clusters from Atlantis II Red Sea brine pool. Microb. Cell Fact. 2019, 18, 56. [Google Scholar] [CrossRef]
- Sekhavati, E.; Jafari, F.; SeyedAlinaghi, S.; Jamalimoghadamsiahkali, S.; Sadr, S.; Tabarestani, M.; Pirhayati, M.; Zendehdel, A.; Manafi, N.; Hajiabdolbaghi, M. Safety and effectiveness of azithromycin in patients with COVID-19: An open-label randomised trial. Int. J. Antimicrob. Agents 2020, 56, 106143. [Google Scholar] [CrossRef]
- Alt, S.; Mitchenall, L.A.; Maxwell, A.; Heide, L. Inhibition of DNA gyrase and DNA topoisomerase IV of Staphylococcus aureus and Escherichia coli by aminocoumarin antibiotics. J. Antimicrob. Chemother. 2011, 66, 2061–2069. [Google Scholar] [CrossRef] [PubMed]
- Some, S.; Bulut, O.; Biswas, K.; Kumar, A.; Roy, A.; Sen, I.K.; Mandal, A.; Franco, O.L.; İnce, İ.A.; Neog, K.; et al. Effect of feed supplementation with biosynthesized silver nanoparticles using leaf extract of Morus indica L. V1 on Bombyx mori L. (Lepidoptera: Bombycidae). Sci. Rep. 2019, 9, 14839. [Google Scholar] [CrossRef] [PubMed]
- Trott, O.; Olson, A. Software news and update AutoDock Vina: Improving the speed and accuracy of docking with a new scoring function. Effic. Optim. Multithreading. 2009, 31, 455–461. [Google Scholar]
- Hosny, S.; Gouda, G.A.; Abu-El-Wafa, S.M. Novel Nano Copper Complexes of a New Schiff Base: Green Synthesis, a New Series of Solid Cr(II), Co(II), Cu(II), Pd(II) and Cd(II) Chelates, Characterization, DFT, DNA, Antitumor and Molecular Docking Studies. Appl. Organomet. Chem. 2022, 36, e6627. [Google Scholar] [CrossRef]
- Gao, Y.; Shang, Q.; Li, W.; Guo, W.; Stojadinovic, A.; Mannion, C.; Man, Y.-G.; Chen, T. Antibiotics for cancer treatment: A double-edged sword. J. Cancer 2020, 11, 5135–5149. [Google Scholar] [CrossRef] [PubMed]
- Solairaj, D.; Rameshthangam, P.; Arunachalam, G. Anticancer activity of silver and copper embedded chitin nanocomposites against human breast cancer (MCF-7) cells. Int. J. Biol. Macromol. 2017, 105, 608–619. [Google Scholar] [CrossRef]
- VT, M.C.; Baccini, C.; Pertici, G.; Serino, L.P.; De Giorgi, U. Anticancer Drug Delivery with Nanoparticles. In Vivo 2006, 20, 697–701. [Google Scholar]

| Wavenumber (cm−1) | Band Assignments | |
|---|---|---|
| Cpx-Drv | Cpx | |
| 3316 | 3389 | Stretching vibration band -N-H |
| 3060 | 3057 | Stretching -C=C-H |
| 2951 | 2922 | Stretching aliphatic -C-H of CH2 “symmetric” |
| 2811 | 2832 | Stretching aliphatic -C-H of CH2 “anti-symmetric” |
| 1728 | 1720 | Stretching vibration -C=O in the carboxylic group |
| 1695 | 1616 | Stretching vibration -C=O of quinoline |
| 1505 | 1586 | Bending vibration -N-H |
| 1361 | 1375 | Hydrated water bending vibration -O-H |
| 1258 | 1257 | Stretching vibration -C-N |
| 1183 | 1176 | Asymmetric -C-O-C |
| 1019 | 1024 | Stretching vibration band -C-F |
| 1004 | 941 | Stretching vibration band C=C bending |
| 826 | 820 | Bending -C=O |
| 806 | ---- | Stretching vibration band -C-Cl |
| 774 | 785 | Bending aromatic -C-H |
| 709 | 713 | Rocking -C-H of >CH2 |
| 596 | 567 | Aromatic -C-H bending |
| wt (mg)/200 mL | 10.00 | 10.01 | 10.02 | 10.01 | 10.00 | 10.01 | 10.00 | 10.05 | 10.51 |
|---|---|---|---|---|---|---|---|---|---|
| Replicate # | Optimum | Analyst 2 | Day 2 | Flow Rate 1.3 mL/min | Flow Rate 1.1 mL/min | ACN % 75% | ACN % 65% | Column-2 | Column-3 |
| 1 | 1057.8 | 1063.2 | 1060.6 | 1017.2 | 1108.3 | 970.2 | 1112.8 | 1080.6 | 1110.5 |
| 2 | 1058.7 | 1060.7 | 1058.3 | 1017.6 | 1104.7 | 971.8 | 1109.8 | 1078.3 | 1107.1 |
| 3 | 1059.2 | 1060.3 | 1056.8 | 1017.0 | 1105.9 | 969 | 1107.7 | 1079.2 | 1105.8 |
| 4 | 1058.2 | 1060.2 | 1056.9 | 1079.8 | 1106.1 | ||||
| 5 | 1060.6 | 1060.5 | 1058.1 | 1093.9 | 1105.0 | ||||
| 6 | 1060.0 | 1060.8 | 1057.4 | 1094.8 | 1104.7 | ||||
| Mean | 1059.1 | 1061.0 | 1058.0 | 1017 | 1106 | 970 | 1110 | 1084 | 1107 |
| STDEV | 1.07 | 1.13 | 1.40 | 0.31 | 1.83 | 1.40 | 2.56 | 7.72 | 2.12 |
| RSD (%) | 0.10 | 0.11 | 0.13 | 0.03 | 0.17 | 0.14 | 0.23 | 0.71 | 0.19 |
| USP tailing | 1.05 | 1.09 | 1.03 | 1.11 | 0.82 | 1.14 | 0.81 | 0.76 | 0.75 |
| Plates | 10,086 | 9906 | 10,054 | 10,095 | 10,081 | 10,012 | 10,068 | 9084 | 10,016 |
| wt (mg)/200 mL | 10.00 | 10.01 | 10.02 | 10.01 | 10.00 | 10.01 | 10.00 | 10.05 | 10.51 |
|---|---|---|---|---|---|---|---|---|---|
| Replicate # | Optimum | Analyst 2 | Day 2 | Flow Rate 1.3 mL/min | Flow Rate 1.1 mL/min | ACN % 75% | ACN % 65% | Column-2 | Column-3 |
| 1 | 1294.7 | 1300.4 | 1295.6 | 1241.0 | 1357.0 | 1198.1 | 1413.8 | 1335.5 | 1332.7 |
| 2 | 1295.8 | 1298.1 | 1293.6 | 1240.7 | 1351.4 | 1195.5 | 1409.1 | 1331.3 | 1327.6 |
| 3 | 1296.4 | 1297.6 | 1292.6 | 1240.9 | 1353.5 | 1195.3 | 1409.4 | 1331.7 | 1328.2 |
| 4 | 1296.2 | 1297.7 | 1291.7 | 1332.4 | 1327.7 | ||||
| 5 | 1296.8 | 1297.8 | 1292.6 | 1337.4 | 1328.0 | ||||
| 6 | 1295.5 | 1297.4 | 1292.1 | 1337.7 | 1327.6 | ||||
| Mean | 1295.9 | 1298.2 | 1293.0 | 1241 | 1354 | 1196 | 1411 | 1334 | 1329 |
| STDEV | 0.74 | 1.12 | 1.41 | 0.15 | 2.83 | 1.59 | 2.63 | 2.90 | 2.01 |
| RSD (%) | 0.06 | 0.09 | 0.11 | 0.01 | 0.21 | 0.13 | 0.19 | 0.22 | 0.15 |
| USP tailing | 1.13 | 1.12 | 1.18 | 1.15 | 1.16 | 1.17 | 1.15 | 1.17 | 1.12 |
| Plates | 11,635 | 11,536 | 11,439 | 11,177 | 11,937 | 10,882 | 12,209 | 11,466 | 11,451 |
| Resolution | 6.995 | 6.85 | 6.93 | 7.04 | 6.81 | 7.35 | 7.25 | 7.15 | 7.11 |
| Concentration (%) | Concentration (µg/mL) | Cpx Mean P. As | Cpx-Drv Mean P. As |
|---|---|---|---|
| 10 | 5 | 114.15 | 136.3 |
| 50 | 25 | 538.35 | 666.4 |
| 70 | 35 | 758.20 | 939.9 |
| 100 | 50 | 1066.35 | 1331.85 |
| 120 | 60 | 1293.65 | 1610.85 |
| 150 | 75 | 1603.50 | 1993.1 |
| 400 | 200 | 4235.20 | 5299.8 |
| Slope | 21.12 | 26.46 | |
| Intercept | 15.06 | 9.93 | |
| Correlation | 0.99999 | 0.99999 | |
| STDEV XY error | 7.30 | 7.21 | |
| LOD (µg/mL) | 1.14 | 0.90 | |
| LOQ (µg/mL) | 3.46 | 2.72 | |
| Accuracy (%) at | 35 µg/mL | 99.8 | 100.5 |
| 50 µg/mL | 99.8 | 98.6 | |
| 60 µg/mL | 100.7 | 100.2 | |
| Item | Cpx | Cpx-Drv | |
|---|---|---|---|
| Repeatability as RSD% | Inter-precision | 0.51, 0.86 | 0.79, 0.30 |
| Intra-precision | 0.71 | 0.57 | |
| Robustness as RSD% | Flow rate | 0.10, 0.03, 0.17 | 0.06, 0.01, 0.21 |
| Organic ratio | 0.10, 0.14, 0.23 | 0.06, 0.13, 0.19 | |
| Ruggedness as RSD% | Analyst to Analyst | 0.10, 0.11 | 0.06, 0.09 |
| Column to Column | 0.10, 0.71, 0.19 | 0.06, 0.22, 0.15 | |
| Day to Day | 0.10, 0.13 | 0.06, 0.11 | |
| Specificity as resolution between both Cpx and Cpx Drv | Acid hydrolysis | 7.84 | |
| Base hydrolysis | 8.05 | ||
| Light degradation | 6.87 | ||
| Antimicrobial Agent | Inhibition Zone Diameter (mm) | |||||
|---|---|---|---|---|---|---|
| Cpx | Cpx-Drv | Fold Increase % | ||||
| Standard Strains | ATCC | 100 y μg/mL | 100 x μg/mL | 50 μg/mL | 25 μg/mL | (x − y)/x∗100 |
| Gram-positive strains | ||||||
| S. aureus | 6538 | 6.7 ± 0.3 | 13.8 ± 0.8 | 7.0 ± 0.5 | 0 | 51.4% |
| B. subtilis | 6633 | 7.8 ± 0.3 | 11.3 ± 0.6 | 9.7 ± 0.8 | 0 | 30.3% |
| Gram-negative strains | ||||||
| E. coli | 8739 | 11.2 ± 0.8 | 15.2 ± 0.3 | 11.7 ± 0.6 | 0 | 26.3% |
| P. aeruginosa | 9027 | 8.7 ± 0.6 | 13.5 ± 0.9 | 10.3 ± 0.3 | 0 | 35.5% |
| B. cepacia | 25,416 | 0 | 10.0 ± 0.9 | 0 | 0 | 100% |
| Yeast strain | ||||||
| C. albicans | 10,231 | 0 | 0 | 0 | 0 | --- |
| Item | Topoisomerase IV IC50 (µg/mL) | DNA Gyrase IC50 (µg/mL) |
|---|---|---|
| Cpx-Drv | 1.913 | 6.754 |
| Cpx | 0.821 | 2.125 |
| # | Types of Interactions | Ligand Interaction | Binding Affinity |
|---|---|---|---|
| Amino Acid Residue | (kcal/mol) | ||
| Cpx | Metal interaction | Mn2+ 2000 | −7.7506 |
| H. bond | Ser 1084 | ||
| Pi−Pi interaction | DG 9 | ||
| Pi−Pi interaction | DT 8 | ||
| Pi−Pi interaction | DC 12 | ||
| Pi−Pi interaction | DA 13 | ||
| Pi−anion interaction | Glu 477 | ||
| Cpx-Drv | Metal interaction | Mn2+ 2000 | −10.3349 |
| H. bond | Ser 1084 | ||
| Pi−Pi interaction | DG 9 | ||
| Pi−Pi interaction | DT 8 | ||
| Pi−Pi interaction | DC 12 | ||
| Pi−Pi interaction | DA 13 | ||
| Pi−anion interaction | Glu 477 | ||
| Halogen interaction | ILE 461 | ||
| Halogen interaction | LYS 460 |
Disclaimer/Publisher’s Note: The statements, opinions and data contained in all publications are solely those of the individual author(s) and contributor(s) and not of MDPI and/or the editor(s). MDPI and/or the editor(s) disclaim responsibility for any injury to people or property resulting from any ideas, methods, instructions or products referred to in the content. |
© 2023 by the authors. Licensee MDPI, Basel, Switzerland. This article is an open access article distributed under the terms and conditions of the Creative Commons Attribution (CC BY) license (https://creativecommons.org/licenses/by/4.0/).
Share and Cite
Al-Hakkani, M.F.; Ahmed, N.; Abbas, A.A.; Hassan, M.H.A.; Aziz, H.A.; Elshamsy, A.M.; Khalifa, H.O.; Abdelshakour, M.A.; Saddik, M.S.; Elsayed, M.M.A.; et al. Synthesis, Physicochemical Characterization using a Facile Validated HPLC Quantitation Analysis Method of 4-Chloro-phenylcarbamoyl-methyl Ciprofloxacin and Its Biological Investigations. Int. J. Mol. Sci. 2023, 24, 14818. https://doi.org/10.3390/ijms241914818
Al-Hakkani MF, Ahmed N, Abbas AA, Hassan MHA, Aziz HA, Elshamsy AM, Khalifa HO, Abdelshakour MA, Saddik MS, Elsayed MMA, et al. Synthesis, Physicochemical Characterization using a Facile Validated HPLC Quantitation Analysis Method of 4-Chloro-phenylcarbamoyl-methyl Ciprofloxacin and Its Biological Investigations. International Journal of Molecular Sciences. 2023; 24(19):14818. https://doi.org/10.3390/ijms241914818
Chicago/Turabian StyleAl-Hakkani, Mostafa F., Nourhan Ahmed, Alaa A. Abbas, Mohammad H. A. Hassan, Hossameldin A. Aziz, Ali M. Elshamsy, Hazim O. Khalifa, Mohamed A. Abdelshakour, Mohammed S. Saddik, Mahmoud M. A. Elsayed, and et al. 2023. "Synthesis, Physicochemical Characterization using a Facile Validated HPLC Quantitation Analysis Method of 4-Chloro-phenylcarbamoyl-methyl Ciprofloxacin and Its Biological Investigations" International Journal of Molecular Sciences 24, no. 19: 14818. https://doi.org/10.3390/ijms241914818
APA StyleAl-Hakkani, M. F., Ahmed, N., Abbas, A. A., Hassan, M. H. A., Aziz, H. A., Elshamsy, A. M., Khalifa, H. O., Abdelshakour, M. A., Saddik, M. S., Elsayed, M. M. A., Sabet, M. A., El-Mokhtar, M. A., Alsehli, M., Amin, M. S., Abu-Dief, A. M., & Mohammed, H. H. H. (2023). Synthesis, Physicochemical Characterization using a Facile Validated HPLC Quantitation Analysis Method of 4-Chloro-phenylcarbamoyl-methyl Ciprofloxacin and Its Biological Investigations. International Journal of Molecular Sciences, 24(19), 14818. https://doi.org/10.3390/ijms241914818

